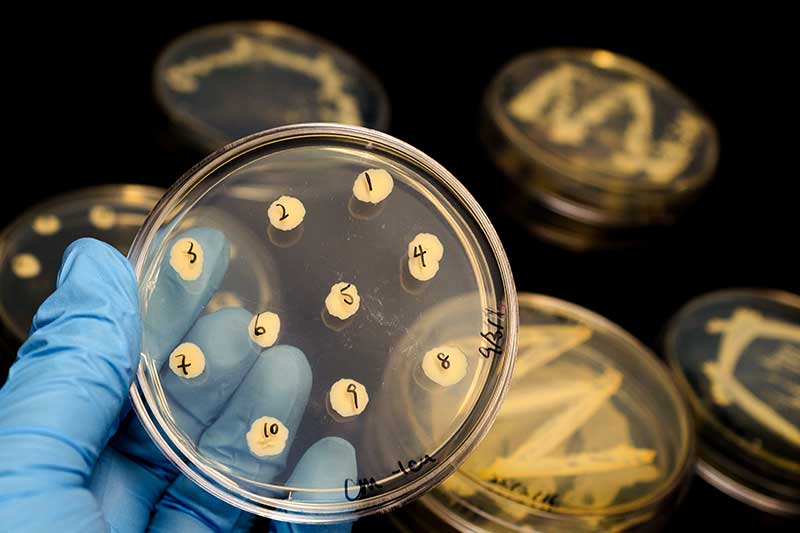

Es gibt einige Dinge, die unser Mikroorganismus so gar nicht mag und die unsere wohlwollenden Mitbewohner im Darm vertreiben. Welche das sind, klären wir in diesem Artikel.
1. Diäten
Eine sehr kalorienreduzierte Ernährungsweise hat tiefgreifende Auswirkungen auf unser Mikrobiom. Durch Diäten hat vor allem der Durchfallkeim Clostridium difficile leichtes Spiel.
Auf diese 7 Diäten solltest du lieber verzichten.
2. Fleisch
Der Verzehr von Fleisch fördert ungünstige Darmbakterien, die den Schadstoff Triethylamin bilden. Die Konsequenz: Chronische Entzündungen können auftreten. Vor allem um rotes und gepökeltes Fleisch sowie geräucherte Wurst solltest du einen großen Bogen machen.
3. Haushaltszucker
Wahrscheinlich ist dir schon bewusst, dass Haushaltszucker kontraproduktiv auf die gesundmachenden Bakterien wirkt. Saccharose nährt Bakterien, die für die Produktion von aggressiven Enzymen verantwortlich sind.
Hier teilen wir 12 Tipps mit dir, um deinen Zuckerkonsum zu reduzieren.
4. Fruchtzucker
Fruktose reduziert die Menge guter Laktobazillen und Bifidobakterien im Darm. Dadurch nimmt die Zahl der Enterokokken zu, sodass das Risiko für Infekte steigt.
5. Junkfood
Pizza, Pommes, Burger und Co. steigern die Anzahl der Keime in der Darmflora, die stille Mikroentzündungen hervorruft. Dies bestätigte das UMCG in Groningen. Fastfood sollte daher nur sehr selten auf deinem Teller landen.
6. Stress
Sind im Blut zu viele Stresshormone im Umlauf, sinkt die bakterielle Ansiedlung. Die Folge: Mehr Krankheitserreger machen sich breit. Mit Ballaststoffen kannst du Stress und Angst erfolgreich entgegenwirken.
7. Schlafmangel
Störend auf das Mikrobiom wirkt sich ebenso zu wenig Schlaf aus. Weniger als 6 Stunden pro Nacht lässt unsere Darmflora bereits nach einem Tag verarmen, so die Nova Southeastern University in Florida.
8. Medikamente
Viele Medikamente bedrohen nachweislich unsere Darmflora. Antibiotika zerstören förderliche Bakterien und ermöglichen, dass sich mehr Schadstoffe einnisten.
9. Zuckeraustauschstoffe
Auch von Light-Produkten solltest du – wenn möglich – die Finger lassen. Schon kleine Mengen von 100 Mikrogramm Süßstoff wirken sich negativ auf unsere Mikroorganismen aus.
10. Infektionen
Ebenso Infektionen wie Atemwegs-Infekte, Entzündungen, Diabetes und Darmkrankheiten beeinträchtigen unsere Darmflora.
So schützt und stärkst du deinen Darm.
11. Alkohol und Rauchen
Je häufiger Alkohol konsumiert wird, desto mehr schwinden die freundlichen Bakterien. Schnaps, Wein und Bier, aber auch Nikotin vernichten die guten Bakterien, worunter beispielsweise die Laktobazillen fallen.
12. Sterile Umgebung
Großflächiges Desinfizieren vertreibt nicht nur schädliche Stoffe, sondern auch gesunde Bakterien. Ein wenig Schmutz ist also kein Problem. Im Gegenteil: Das Mikrobiom freut sich. 😉
13. Übergewicht
Menschen, die zu viel auf die Waage bringen, müssen sich mit einer geringeren Artendiversität der Darmflora zufriedengeben. Dies bestätigt eine aktuelle Erhebung der Christian-Albrechts-Universität in Kiel.
Fazit: Störenfriede für unsere Darmflora
Jetzt kennst du die größten Störfaktoren, die einen nachteiligen Effekt auf unser Mikrobiom haben. Vermeidest du diese weitgehend, stärkst du zugleich die gesundmachenden Mikroorganismen und damit deine Gesundheit! 😊